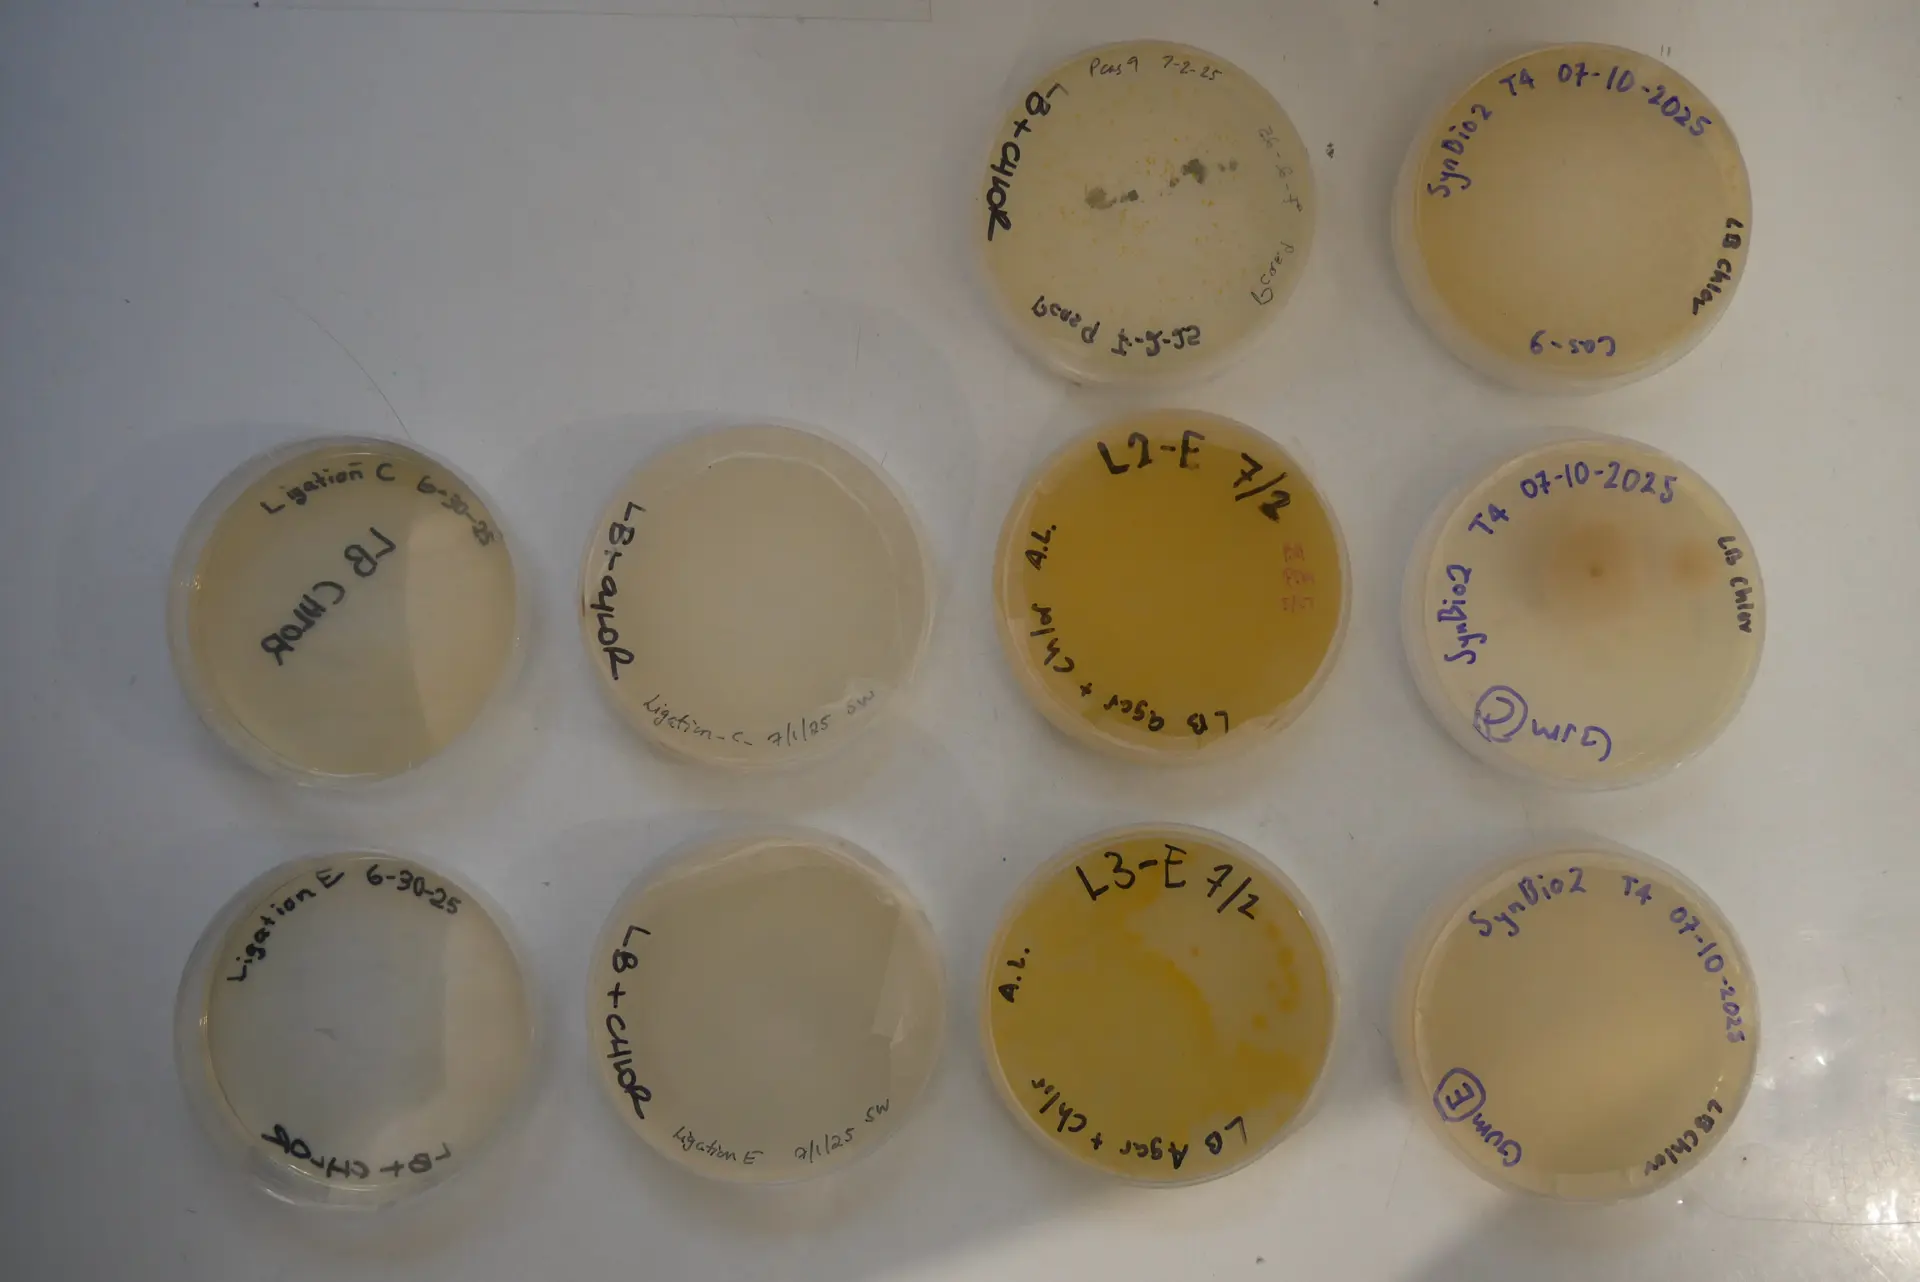
Maxiprep bind/clean columns
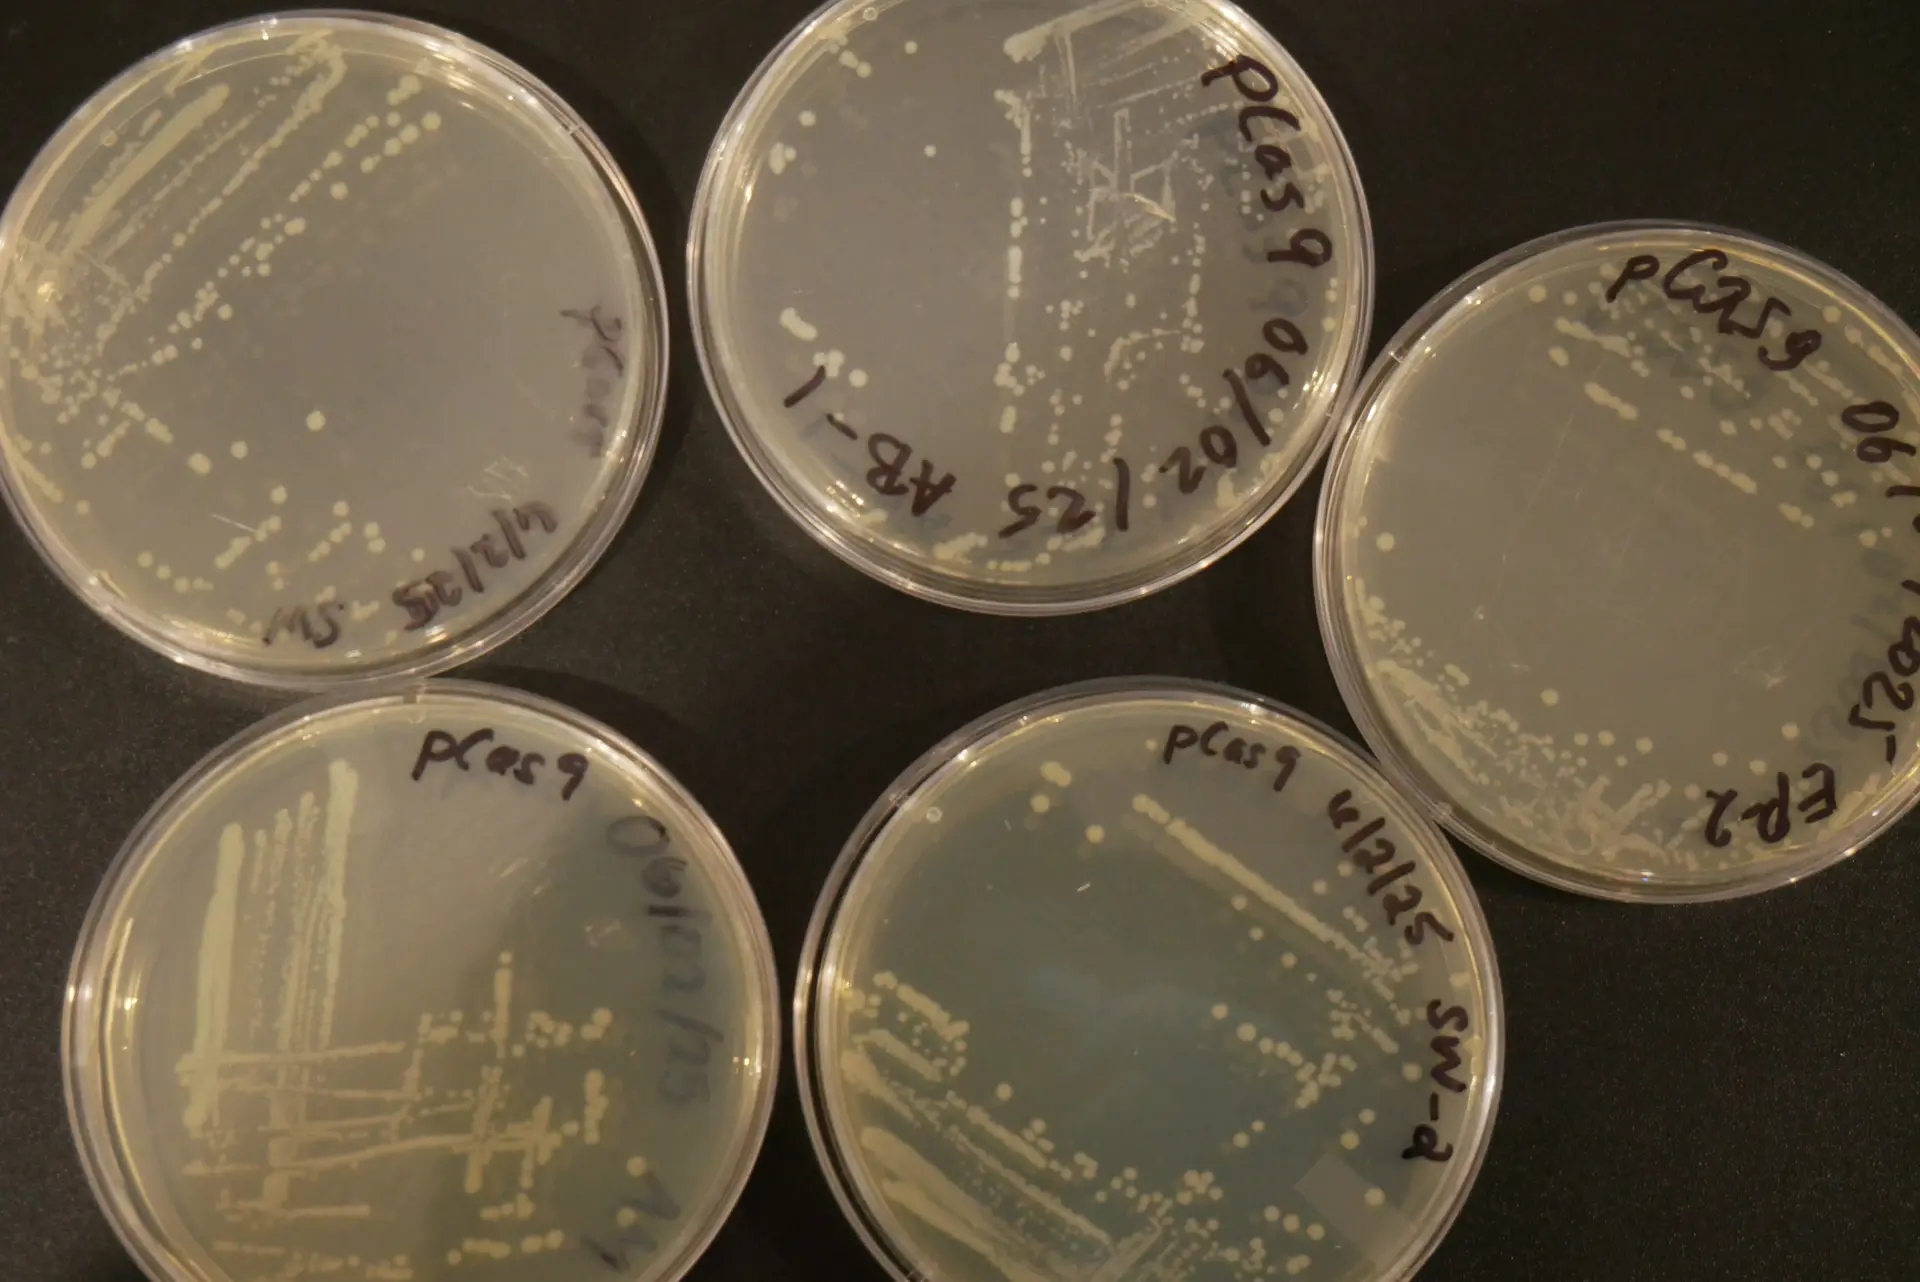
Colonies
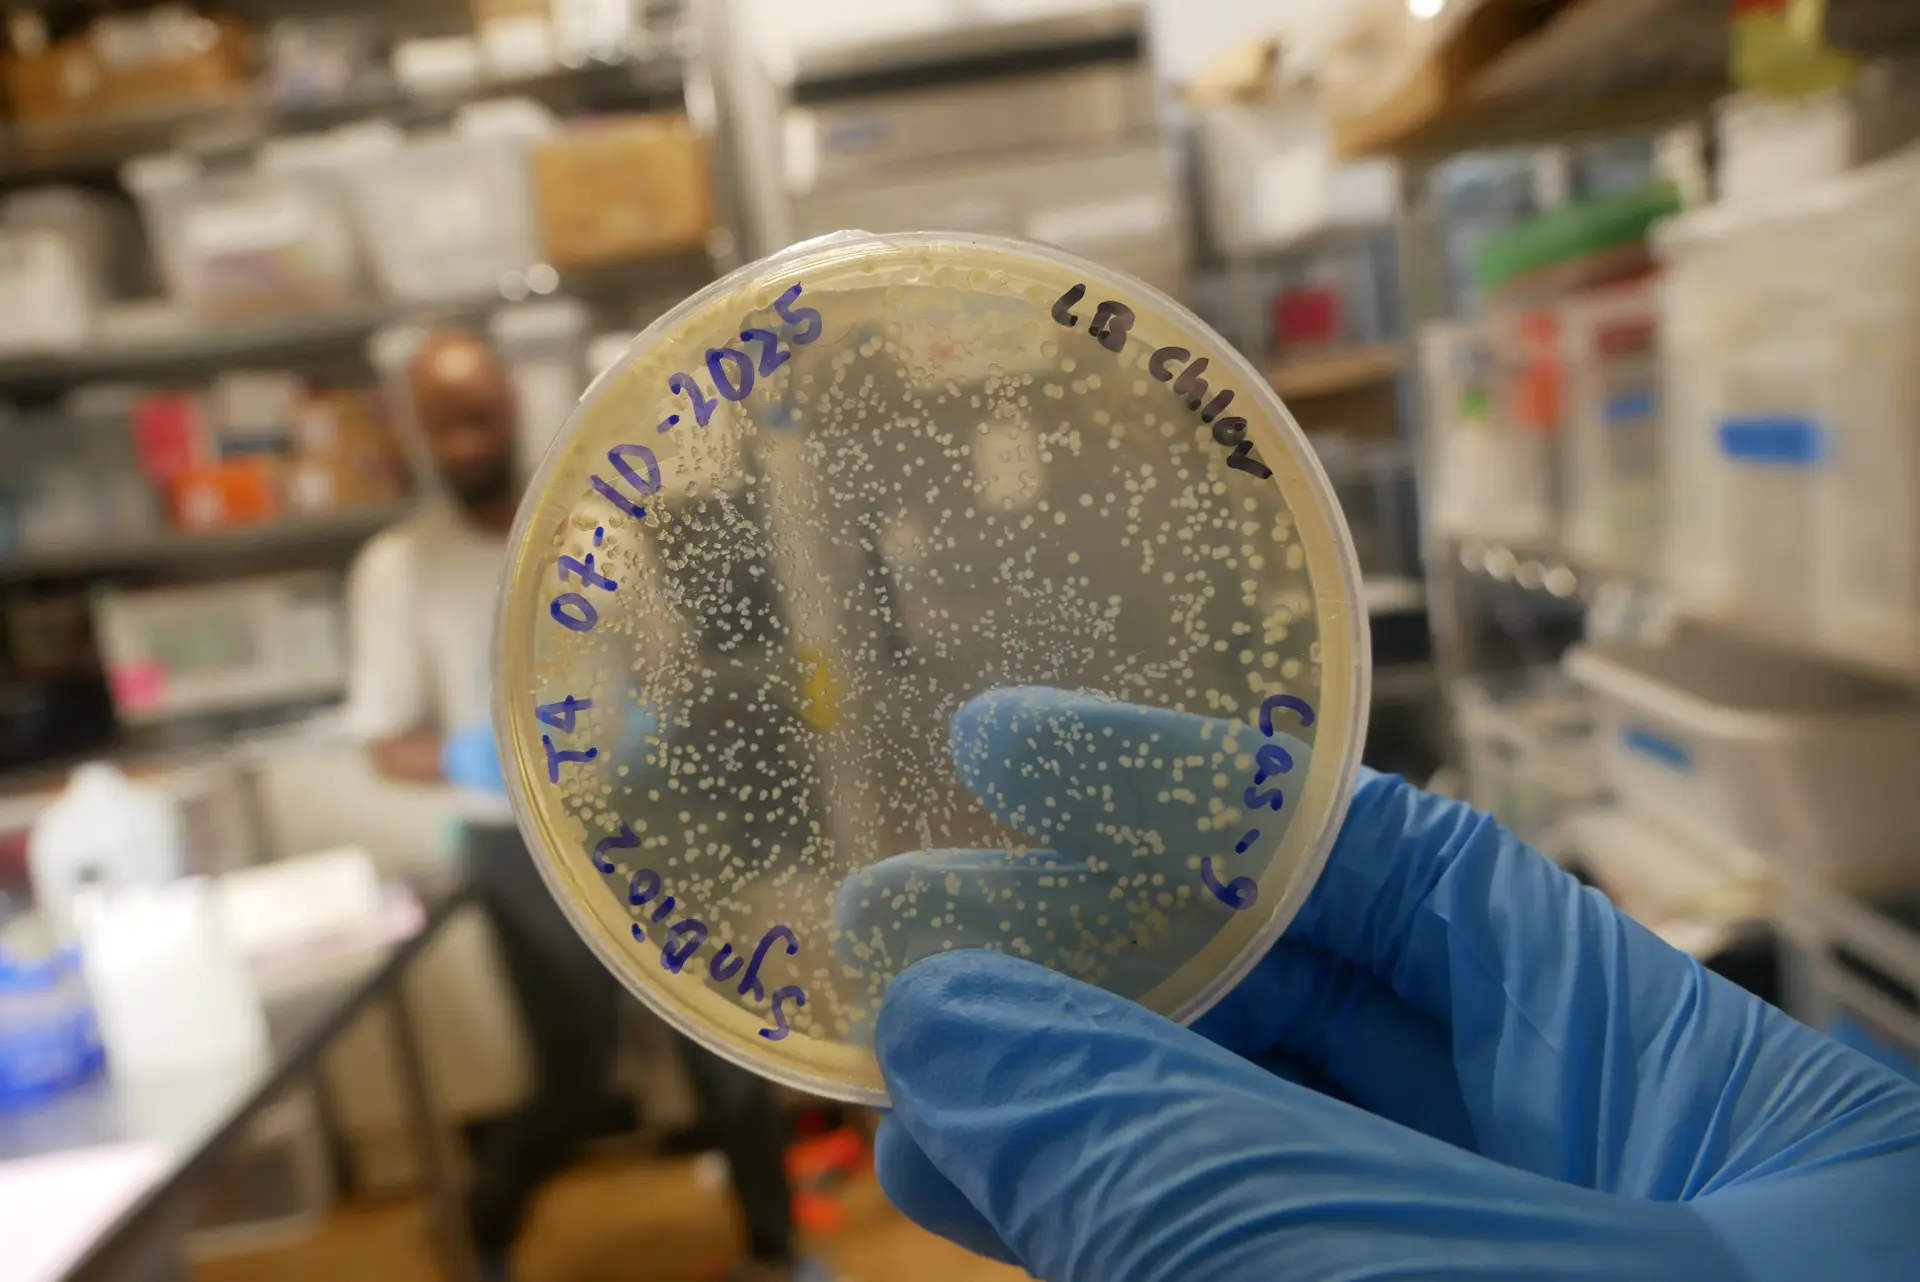
Gel showing low DNA
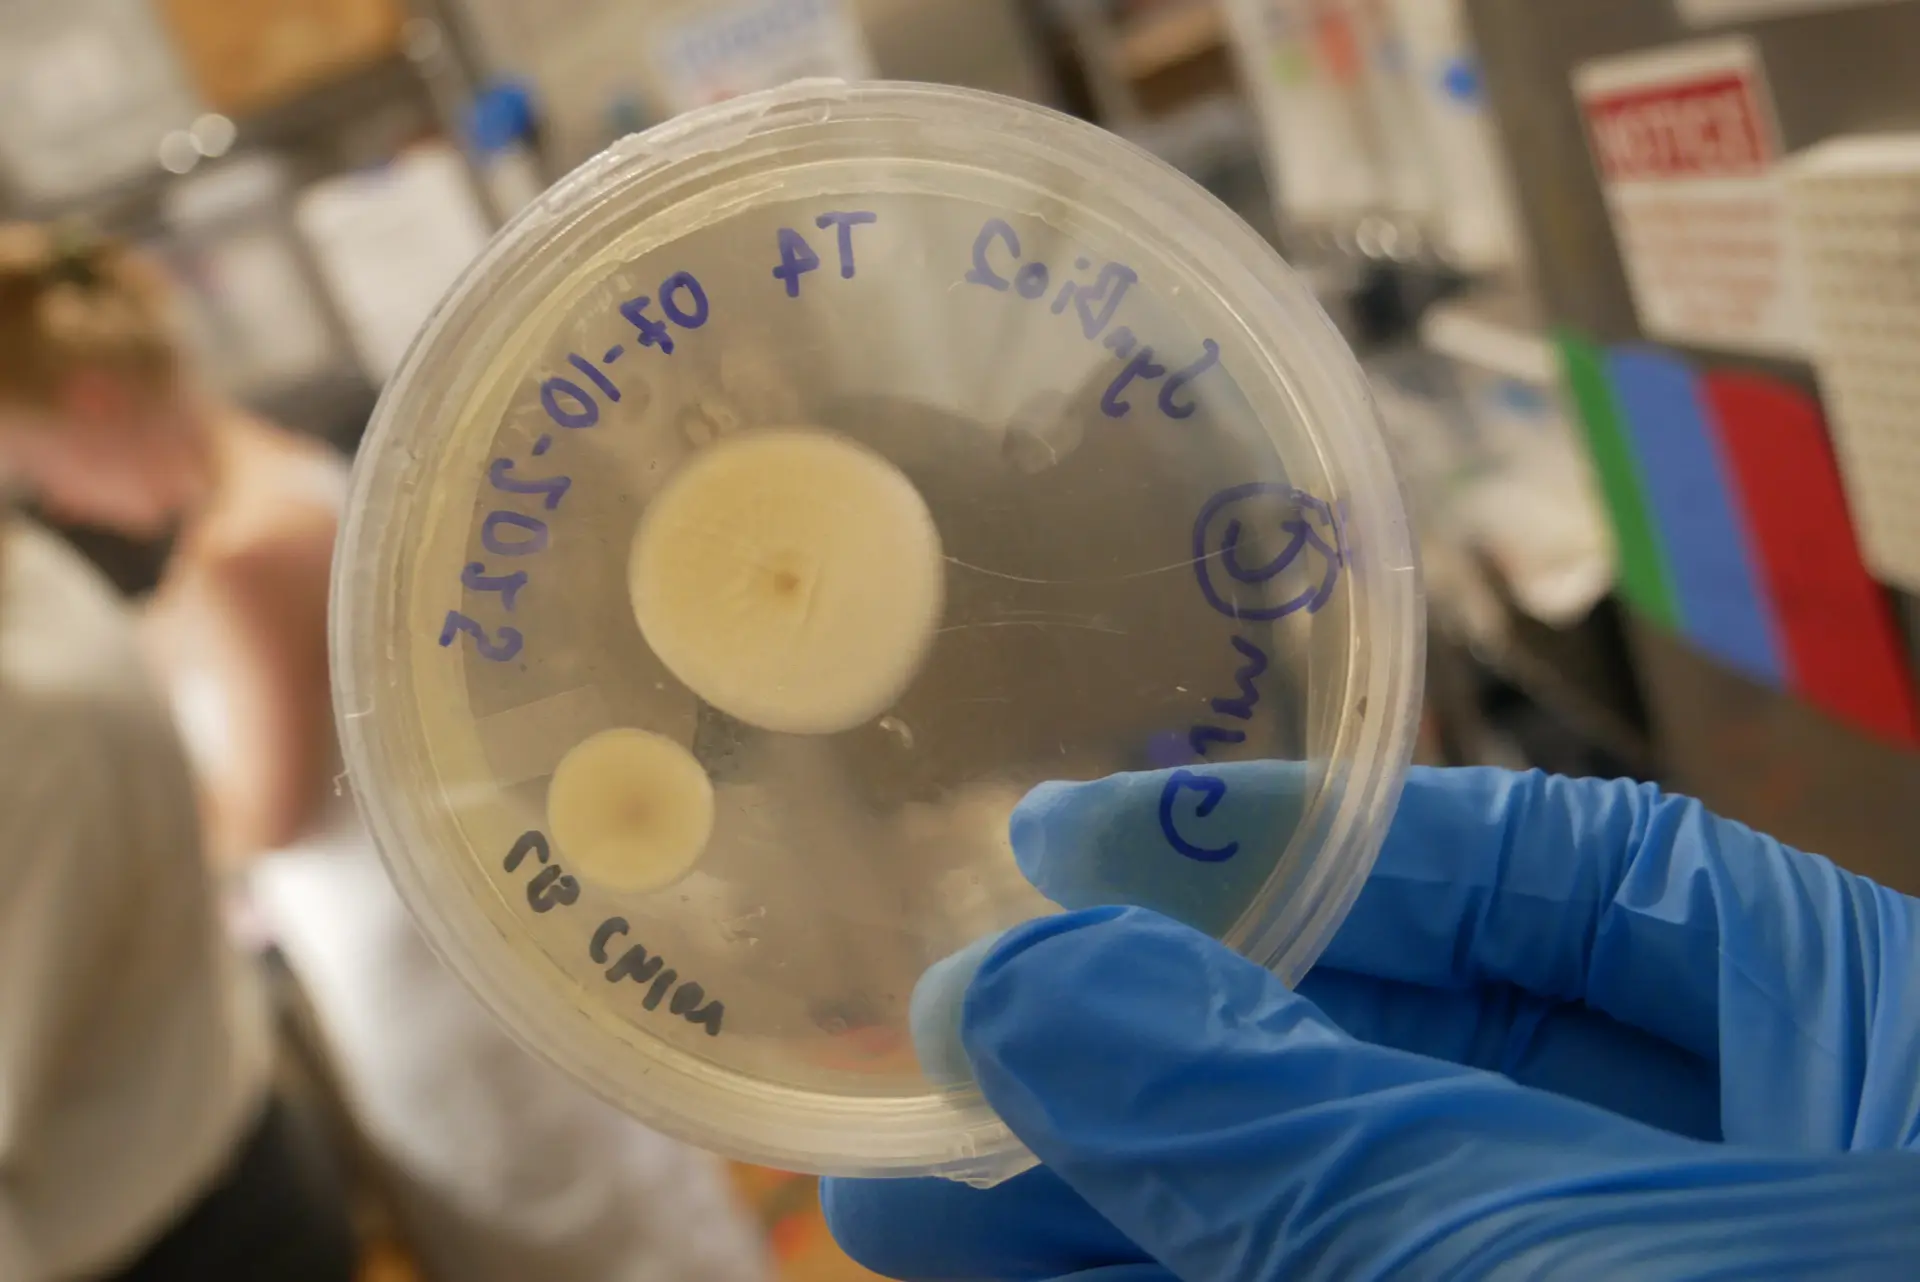
Sequencing fail
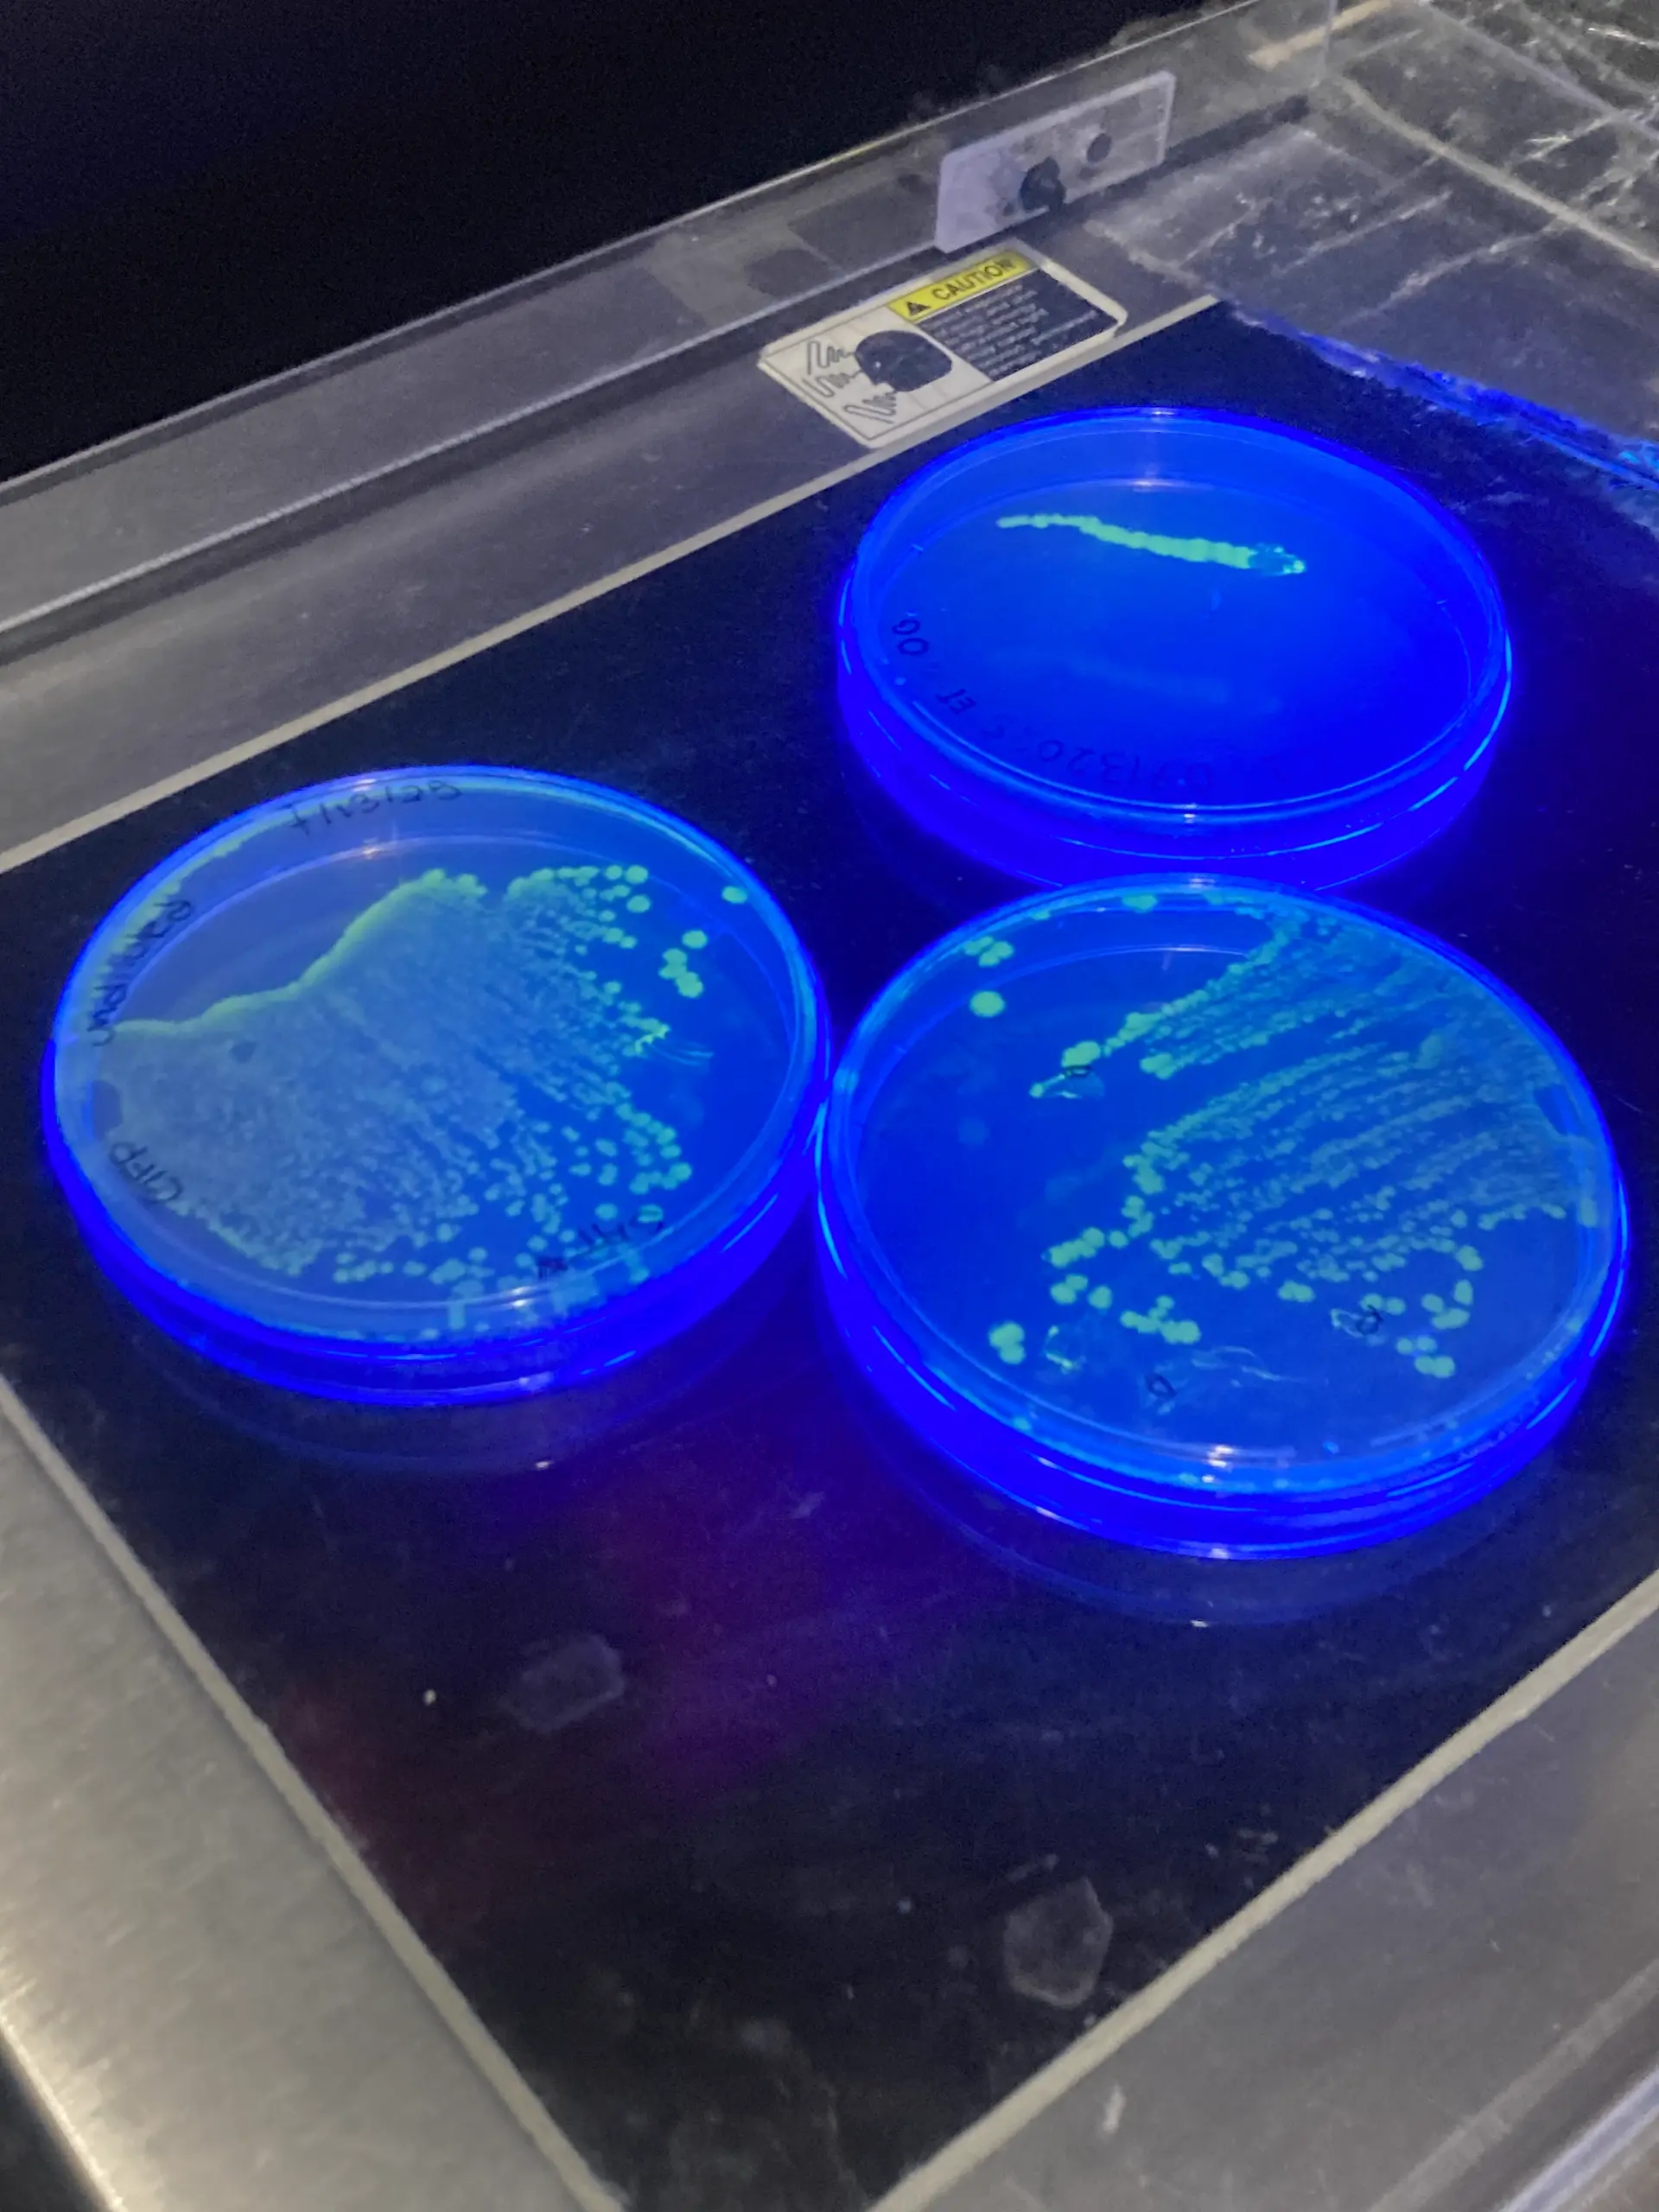
Control plate

Bacterial Leaf Scorch and Xylella Fastidiosa
Bacterial Leaf Scorch (BLS) is a plant disease caused by the bacterium Xylella fastidiosa. It poses a growing threat to vegetation by forming harmful biofilms that block water and mineral pathways and resist plant immune defenses. BLS impacts plants, trees, and crops, causing reduced agricultural yields, declines in urban canopy health, and big-time economic harms for farmers.
BLS is spreading alongside the emergence of agricultural monocultures and loss of genetic diversity among plants. The experiment my labmates and I did explored how bioengineering tools can offer targeted and sustainable solutions to plant diseases.

.
When biological foundations are disrupted, people lose the psychic structures that help them make sense of reality.
Petri Colonies